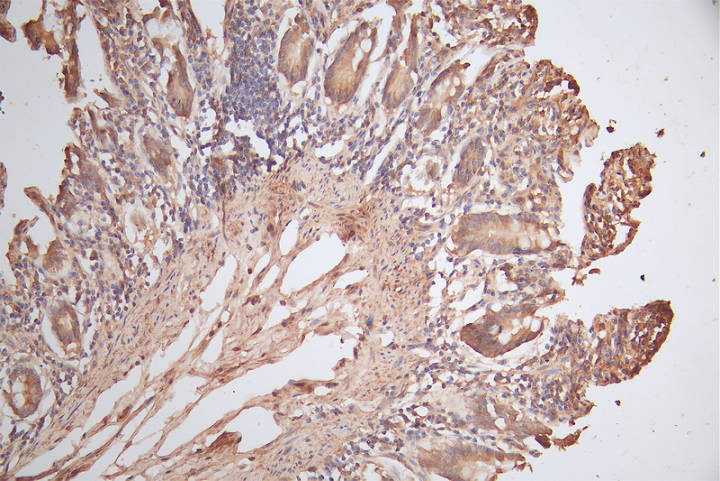

HMGCR Antibody
-
中文名稱:HMGCR兔多克隆抗體
-
貨號:CSB-PA010565LA01HU
-
規格:¥440
-
圖片:
-
Western Blot
Positive WB detected in: HepG2 whole cell lysate, JK whole cell lysate,PC-3 whole cell lysate,Mouse Brain tissue lysate, Mouse Liver tissue lysate
All lanes: HMGCR antibody at 1:1000
Secondary
Goat polyclonal to rabbit IgG at 1/50000 dilution
Predicted band size: 98 kDa
Observed band size: 100 kDa -
IHC image of CSB-PA010565LA01HU diluted at 1:150 and staining in paraffin-embedded human small intestine tissue performed on a Leica BondTM system. After dewaxing and hydration, antigen retrieval was mediated by high pressure in a citrate buffer (pH 6.0). Section was blocked with 10% normal goat serum 30min at RT. Then primary antibody (1% BSA) was incubated at 4°C overnight. The primary is detected by a biotinylated secondary antibody and visualized using an HRP conjugated SP system.
-
IHC image of CSB-PA010565LA01HU diluted at 1:150 and staining in paraffin-embedded human liver cancer performed on a Leica BondTM system. After dewaxing and hydration, antigen retrieval was mediated by high pressure in a citrate buffer (pH 6.0). Section was blocked with 10% normal goat serum 30min at RT. Then primary antibody (1% BSA) was incubated at 4°C overnight. The primary is detected by a biotinylated secondary antibody and visualized using an HRP conjugated SP system.
-
-
其他:
產品詳情
-
產品描述:
The HMGCR polyclonal antibody was generated by inoculating a rabbit with recombinant human 3-hydroxy-3-methylglutaryl-coenzyme A reductase protein (588-887aa). The resulting antibodies were extracted from the rabbit serum and purified using protein G affinity chromatography.
With a purity level exceeding 95%, this HMGCR polyclonal antibody contains minimal impurities. It can recognize and bind to human HMGCR protein. Its effectiveness has been validated in various experimental settings, including ELISA, IHC, and IF, allowing for the detection of levels and analysis of the distribution of the HMGCR protein.
-
產品名稱:Rabbit anti-Homo sapiens (Human) HMGCR Polyclonal antibody
-
Uniprot No.:
-
基因名:
-
別名:3 hydroxy 3 methylglutaryl CoA reductase antibody; 3 hydroxy 3 methylglutaryl Coenzyme A reductase antibody; 3 hydroxymethylglutaryl CoA reductase antibody; 3-hydroxy-3-methylglutaryl CoA reductase (NADPH) antibody; 3-hydroxy-3-methylglutaryl-coenzyme A reductase antibody; 3H3M antibody; HMDH_HUMAN antibody; HMG CoA reductase antibody; HMG CoAR antibody; HMG-CoA reductase antibody; Hmgcr antibody; Hydroxymethylglutaryl CoA reductase antibody; LDLCQ3 antibody; MGC103269 antibody; Red antibody
-
宿主:Rabbit
-
反應種屬:Human, Mouse
-
免疫原:Recombinant Human 3-hydroxy-3-methylglutaryl-coenzyme A reductase protein (588-887AA)
-
免疫原種屬:Homo sapiens (Human)
-
標記方式:Non-conjugated
本頁面中的產品,HMGCR Antibody (CSB-PA010565LA01HU),的標記方式是Non-conjugated。對于HMGCR Antibody,我們還提供其他標記。見下表:
-
克隆類型:Polyclonal
-
抗體亞型:IgG
-
純化方式:>95%, Protein G purified
-
濃度:It differs from different batches. Please contact us to confirm it.
-
保存緩沖液:Preservative: 0.03% Proclin 300
Constituents: 50% Glycerol, 0.01M PBS, PH 7.4 -
產品提供形式:Liquid
-
應用范圍:ELISA, WB, IHC
-
推薦稀釋比:
Application Recommended Dilution WB 1:500-1:2000 IHC 1:200-1:500 -
Protocols:
-
儲存條件:Upon receipt, store at -20°C or -80°C. Avoid repeated freeze.
-
貨期:Basically, we can dispatch the products out in 1-3 working days after receiving your orders. Delivery time maybe differs from different purchasing way or location, please kindly consult your local distributors for specific delivery time.
-
用途:For Research Use Only. Not for use in diagnostic or therapeutic procedures.
相關產品
靶點詳情
-
功能:Catalyzes the conversion of (3S)-hydroxy-3-methylglutaryl-CoA (HMG-CoA) to mevalonic acid, the rate-limiting step in the synthesis of cholesterol and other isoprenoids, thus plays a critical role in cellular cholesterol homeostasis. HMGCR is the main target of statins, a class of cholesterol-lowering drugs.
-
基因功能參考文獻:
- High HMGR expression is associated with breast cancer metastasis. PMID: 29626418
- High HMGCR expression is associated with hypercholesterolemia. PMID: 29678744
- The presence of rs17244841 ve rs17238540 mutations in HMGCR causes a significant reduction in total cholesterol and LDL-c levels. PMID: 29096742
- A positive relationship emerged between HMG-CoAR, hormone receptors and TAZ/YAP, suggesting a connection between the mevalonate pathway, the hormonal milieu and Hippo in Male breast cancer. Moreover, HMG-CoAR expression may be a favorable prognostic indicator. PMID: 27713571
- HMGCR genetic variation is associated with Alzheimer's disease. PMID: 26950278
- our study demonstrates A allele of HMGCR rs3846662 acts as a protective factor for late-onset Alzheimer's disease in northern Han Chinese PMID: 27009838
- UBXD8 is necessary for sterol-stimulated dislocation of ubiquitylated HMGCR from the endoplasmic reticulum membrane en route to proteasomal degradation, a function dependent on its UBX domain. PMID: 28882874
- The docking studies indicate rutin as the best compound that can inhibit HMG-CoA reductase as it had strong binding affinity to the enzyme. PMID: 27216569
- Both HMGCR and SQLE promoters have two SREs that may act as a homing region to attract a single SREBP-2 homodimer. PMID: 28342963
- To estimate the association between changes in levels of LDL-C (and other lipoproteins) and the risk of cardiovascular events related to variants in the CETP gene, both alone and in combination with variants in the 3-hydroxy-3-methylglutaryl-CoA reductase (HMGCR) gene. PMID: 28846118
- Low LDL cholesterol levels due to PCSK9 and HMGCR variants had no causal effect on high risk of Alzheimer's disease, vascular dementia, any dementia, or Parkinson's disease; however, low LDL cholesterol levels may have a causal effect in reducing the risk of Alzheimer's disease. PMID: 28438747
- TGF-beta1 induces cholesterol synthesis by increasing HMG-CoA reductase mRNA expression in keratinocytes. PMID: 26932266
- Gene expression profile and the biological functions of HMGCR in gastric cancer were studied. It was found that the expression of HMGCR was increased in gastric cancer tissues. Over-expression of HMGCR promoted the growth and migration of gastric cancer cells, while knocking down the expression of HMGCR inhibited the growth, migration and tumorigenesis of gastric cancer cells. PMID: 27085483
- In this study, variants in PCSK9 had approximately the same effect as variants in HMGCR on the risk of cardiovascular events and diabetes per unit decrease in the LDL cholesterol level. The effects of these variants were independent and additive. PMID: 27959767
- Data show that simvastatin significantly inhibited cellular proliferation, induced cell cycle G1 arrest and apoptosis, and caused cellular stress via reduction in the enzymatic activity of 3-hydroxy-3-methyl-glutaryl-CoA reductase (HMGCR). PMID: 26503475
- no associations found between HMGCR rs3846662, HMRCR alternative splicing and Alzheimer's disease pathology pathology. PMID: 26541602
- results indicate that abnormal lipid metabolism may exist in spontaneous preterm delivery (SPTD) women and the premature fetus and the HMGCR gene may be a susceptible gene for SPTD PMID: 26301579
- Report the mechanism of polyphenol binding to and activity regulation of HMGR using molecular docking. PMID: 26357462
- the results of the present study showed that luteolin modulates HMGCR transcription by decreasing the expression and nuclear translocation of SREBP-2. PMID: 26302339
- Discovery new drug candidates for inhibition of human HMG-CoA reductase through structure-based virtual screening. PMID: 26170618
- Results show that HMGCR rs3846662 acts as a potent genetic modifier for Alzheimer's disease risk, age of onset and conversion from mild cognitively impairment PMID: 25023145
- study demonstrated the oncogenic roles of HMGCR in glioblastoma cells and HMGCR might be a promising therapeutic target. PMID: 26432005
- the 5-aminoimidazole-4-carboxyamide ribonucleoside (AICAR)-induced activation of AMPK directly inhibited the expression of SREBP-2 and HMGCR and HMGCS, and suppressed the TSH-stimulated up-regulation of SREBP-2 in HepG2 cells. PMID: 25933205
- Data show that sterols stimulate binding of prenyltransferase UBIAD1 to HMG CoA reductase, which is subject to sterol-accelerated, endoplasmic reticulum (ER)-associated degradation augmented by the nonsterol isoprenoid geranylgeraniol. PMID: 25742604
- Human carotid atherosclerotic lesion protein components decrease cholesterol biosynthesis rate in macrophages through 3-hydroxy-3-methylglutaryl-CoA reductase regulation. PMID: 25639207
- miR-21 regulates triglyceride and cholesterol metabolism in non-alcoholic fatty liver disease by targeting HMGCR PMID: 25605429
- The effect of lower LDL-C on the risk of coronary heart disease mediated by polymorphisms in NPC1L1, HMGCR, or both is approximately the same per unit lower LDL-C and log-linearly proportional to the absolute exposure to lower LDL-C. PMID: 25770315
- promoter DNA hypermethylation of the ABCG1 and GALNT2 genes, but not the HMGCR gene, is associated with an increased risk of CHD. PMID: 25084356
- Strong HMGCR expression is associated with high response to radiotherapy in ductal carcinoma-in situ. PMID: 24777857
- The results show that carriage of SNPs in the HMGCR gene were associated with bodyweight gain and increased risk of type 2 diabetes PMID: 25262344
- HMGCR is differentially expressed in colorectal cancer and that positive expression is associated with favourable tumour characteristics and a prolonged survival in unadjusted analysis. PMID: 24708688
- HMGCR is upregulated in hepatocellular carcinoma associated with paraneoplastic hypercholesterolemia. PMID: 23549978
- findings show that HNRNPA1 modulates the expression level of an alternatively spliced transcript of HMGCR by regulating splicing and altering RNA stability, resulting in reduced HMGCR enzyme activity and increased LDL-Cholesterol uptake PMID: 24001602
- Data indicate that RNAi-mediated knockdown of VCP/p97 blocks sterol-accelerated degradation but not ubiquitination of 3-hydroxy-3-methylglutaryl coenzyme A reduc (HMG CoA reductase) in SV-589 cells. PMID: 24025715
- HMGCR-mediated changes in F-actin structure play an important role in the inter-cellular transmission of respiratory syncytial virus infection. PMID: 23994498
- Over-expression of HMGCR in esophageal squamous cell carcinoma (ESCC) cells promoted cell growth and migration. PMID: 24390662
- knockdown of MARCH6 also controls the level of 3-hydroxy-3-methyl-glutaryl coenzyme A reductase (HMGCR) in hepatocytes and model cell lines PMID: 24449766
- Increased cholesterol synthesis mediated by HMGCoA-R under inflammatory stress may be one of the mechanisms for intracellular lipid accumulation and statin resistance. PMID: 24233489
- Age and sex modify the contribution of the HMGCR-911 polymorphism to fasting serum total cholesterol, LDL-cholesterol levels and risk of coronary heart disease. PMID: 23933271
- These results suggest that dengue virus infection increases intracellular cholesterol levels at early times post infection by triggering the modulation of LDL particles uptake and the increase in the enzymatic activity of HMG-CoA reductase. PMID: 23642566
- A novel role for Aup1 in maintenance of intracellular cholesterol homeostasis via mediation of the endoplasmic reticulum associated degradation of HMG-CoA reductase. PMID: 23223569
- Statins up-regulate the expression of HMGCR, the major target of autoantibodies in statin-associated immune-mediated necrotizing myopathy. PMID: 21360500
- The association of HMGCR promoter region polymorphisms with cholesterol levels and coronary artery disease in patients from Western India are reported. PMID: 22858685
- This study was designed to understand the mode of interactions of HMGCR isoform 2 with statins Atorvastatin, Lovastatin, Fluvastatin, Simvastatin, Pravastatin, Rosuvastatin and Cerivastatin. PMID: 22177940
- The HMGCR rs3846662 GG genotype was quantitatively documented to be a significant determinant for higher LDL-C level in basal state and possibly in response to atorvastatin. PMID: 21427285
- Reductions in plasma insulin may have affected the expression of a key regulatory gene of cholesterol synthesis, HMG-CoA reductase and low-density lipoprotein receptor. PMID: 22024489
- HMG-CoA reductase activation and urinary pellet cholesterol elevations in acute kidney injury. PMID: 21799150
- HMG-CoA reductase regulation takes place at the levels of transcription, translation, post-translational modification and degradation. (Review) PMID: 21801748
- Linalool reduces the expression of 3-hydroxy-3-methylglutaryl CoA reductase via sterol regulatory element binding protein-2- and ubiquitin-dependent mechanisms. PMID: 21944868
- inhibition of protein geranylgeranylation markedly attenuated ubiquitylation and dislocation, implicating for the first time a geranylgeranylated protein(s) in the metabolically regulated ERAD of HMGR. PMID: 21778231
顯示更多
收起更多
-
亞細胞定位:Endoplasmic reticulum membrane; Multi-pass membrane protein. Peroxisome membrane; Multi-pass membrane protein.
-
蛋白家族:HMG-CoA reductase family
-
組織特異性:[Isoform 1]: Ubiquitously expressed with the highest levels in the cerebellum, fetal brain, testis, skin and adrenal gland.; [Isoform 2]: Detected in the cerebellum, fetal brain, testis and adrenal gland.; [Isoform 3]: Low abundance except in skin, esopha
-
數據庫鏈接:
Most popular with customers
-
-
YWHAB Recombinant Monoclonal Antibody
Applications: ELISA, WB, IHC, IF, FC
Species Reactivity: Human, Mouse, Rat
-
Phospho-YAP1 (S127) Recombinant Monoclonal Antibody
Applications: ELISA, WB, IHC
Species Reactivity: Human
-
-
-
-
-